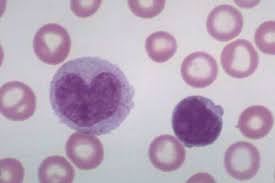

“Assalamualaikum Dr Zubaidi. Saya Anis, sedang hamil anak pertama 34 minggu dan baru-baru ini saya demam, batuk dan selesema. Saya ke hospital dan cek darah. Jumlah platelet sy 151 dan border line untuk kena denggi. So doktor masuk air dan hantar ke darah ke makmal untuk kali kedua. Bacaan platelet 155. Dua hari selepas itu saya diperiksa darah lagi dan bacaan platelet menurun lagi ke 134.
Adakah keadaan ni merbahaya untuk saya dan baby dan macam mana untuk menaikkan bilangan platelet dalam darah. Combo test untuk denggi semuanya negative, tapi platelet rendah. Harap doktor dapat bantu saya. terima kasih.”
Jawapan:
WA ALAIKUM MUS SALAM.
Saya percaya puan mungkin dijangkiti oleh kuman virus yang biasa menjangkiti saluran pernafasan. Itu yang menyebabkan puan mengalami demam, batuk dan selsema.
Saya ingin membetulkan fakta, iaitu penurunan bilangan sel platelet bukanlah petunjuk untuk jangkitan denggi. Ia mungkin hanya menunjukkan puan mengalami jangkitan virus. Sementara jangkitan denggi adalah sebahagian jangkitan virus, itu yang menyebabkan bilangan sel platelet puan menjadi rendah.
Platelet adalah sel-sel dalam darah yang membantu darah membeku. Bilangan sel platelet yang normal adalah antara 150 dan 400 juta setiap mililiter (ml) darah.
Apabila bilangannya terlalu banyak, ia akan menyebabkan darah menjadi cepat membeku dan membentuk darah beku. Darah beku akan menyebabkan peredaran darah menjadi terganggu. Dibimbangi apabila darah beku yang bergerak ke saluran darah yang lebih kecil, menyebabkan saluran darah tersebut tersumbat.
Jika bilangannya menjadi rendah, ia menyebabkan darah menjadi ‘cair’ dan menyebabkan darah sukar membeku. Bila berlaku pendarahan, ia sukar dihentikan.
Kebanyakan wanita hamil mempunyai bilangan sel platelet yang normal. Namun ada sebilangannya (kurang dari sepuluh peratus) yang mengalami sedikit penurunan dalam kiraan sel platelet mereka. Keadaan ini normal jika bilangan platelet berada di antara 100 dan 150 juta platelet per ml darah. Tidak perlu berbuat apa-apa, hanya perlu memantau keadaan ini, agar bilangan platelet itu tidak terus berkurangan.
Saya mencadangkan puan minum air mineral yang mencukupi. Ia akan membantu tubuh kita meningkat imun (daya tahan tubuh melawan penyakit) dan mempercepatkan penyembuhan dari jangkitan virus.
Kenapa ia berlaku?
Bilangan sel platelet yang kurang dari bacaan normal ketika seorang wanita itu sedang hamil, dinamakan “Gestational Thrombocytopenia”. Ia biasanya berlaku pada selepas minggu kehamilan minggu ke 20. Ia tidak akan menjejaskan bayi dalam rahem dan tahap platelet akan kembali normal apabila bayi dilahirkan.
Badan kita secara semula jadi akan memusnahkan sel-sel platelet yang tidak digunakan, dan menggantikan sel-sel platelet lama dengan sel-sel platelet yang baru. Ketika seorang wanita itu hamil, proses ini dipercepatkan. Tujuannya agar bila berlaku pendarahan ketika hamil, ia dapat dihentikan dengan segera.
Namun ketika hamil, tubuh wanita itu akan mempunyai kandungan cecair yang lebih banyak. Oleh itu mereka kelihatan lebih besar dan berat. Cecair dalam darah ini akan “mencairkan” darah. Ini bermakna walaupun bilangan sel platelet itu normal, tetapi disebabkan oleh kuantiti air yang banyak, bilangan platelet menjadi lebih rendah jika dikira dalam setiap milliliter darah. Oleh kerana bilangan sebenarnya masih sama, keadaan ini tidak menjejaskan bagaimana platelet berfungsi.
Jika bacaan sel platelet adalah amat rendah (kurang dari 100 juta dalam satu milliliter), ia adalah sesuatu yang tidak normal. Ia mungkin menyebabkan wanita yang hamil ini untuk mengalami masalah darah sukar untuk berhenti terutama ketika proses kelahiran atau selepas proses kelahiran, terutama jika berlakunya kelahiran secara pembedahan Caesarean.
Oleh itu jika bacaan sel platelet menjadi kurang dari 100 juta per ml darah, ia menunjukkan wanita ini mempunyai risiko pendarahan. Beliau harus melakukan ujian tambahan bagi menentukan sama ada ia disebabkan oleh masalah penyakit lain yang lebih serius.
Antara masalah penyakit yang menyebabkan penurunan bilangan sel platelet yang terlalu rendah ialah penyakit lupus akibat sistem imun (pertahanan tubuh) menyerang sel-sel tubuh sendiri. Ini menyebabkan kemusnahan sel-sel platelet dan menjadikan bilangannya rendah.
Ia juga boleh disebabkan oleh komplikasi akibat masalah pre-eclampsia yang dapat dikesan apabila tekanan darah menjadi tinggi dan terdapat protein dalam air kencing.
Oleh itu selalulah berbincang dengan doctor mengenai masalah ini bagi memastikan kehamilan selamat. Pastikan penurunan sel platelet ini bukan disebabkan oleh masalah penyakit yang berbahaya.
Wallahu a’lam.
KONSULTASI BERSAMA DR ZUBAIDI
Jika berminat mendapatkan konsultasi 20 minit bersama Dr Zubaidi, boleh klik di link :
Dr Zubaidi Hj Ahmad Menulis Perkongsian Pengetahuan dan Pengalaman